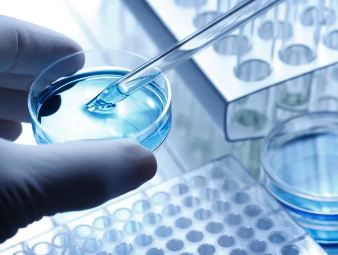
image.png

湖南培養(yǎng)干細胞的作用是什么,有哪些應用
2024-11-15 15:35:13 來源: 小編 咨詢醫(yī)生
湖南作為中國生物科技的重要基地,近年來在干細胞研究領域取得了顯著成就。下面將從湖南培養(yǎng)干細胞的作用及其應用方面進行詳細探討,以期為讀者提供專業(yè)且有深度的見解。
首先,我們來了解一下干細胞的基本概念。干細胞是一種具有自我更新和分化潛能的細胞,可以分為胚胎干細胞、成體干細胞和誘導多能干細胞等類型。它們在人體發(fā)育、組織修復和疾病治療等方面具有重要作用。
一、湖南培養(yǎng)干細胞的作用
1.促進生物醫(yī)藥產(chǎn)業(yè)發(fā)展:湖南培養(yǎng)干細胞技術(shù)有助于推動生物醫(yī)藥產(chǎn)業(yè)的快速發(fā)展。通過干細胞技術(shù),可以開發(fā)出更多具有臨床應用價值的生物藥品,為患者提供更有效的治療手段。
2.提高疾病治愈率:湖南培養(yǎng)干細胞可以用于治療多種疾病,如心臟病、神經(jīng)系統(tǒng)疾病、血液病等。這些疾病傳統(tǒng)治療方法效果有限,而干細胞療法為這些疾病的治療帶來了新的希望。
3.促進組織修復與再生:湖南培養(yǎng)干細胞技術(shù)可應用于組織修復與再生,如皮膚損傷、神經(jīng)損傷、軟骨損傷等。通過培養(yǎng)干細胞,可以修復受損組織,恢復其功能。
4.探索生命奧秘:湖南培養(yǎng)干細胞技術(shù)有助于科學家研究人體發(fā)育、細胞分化等生命過程,為揭示生命奧秘提供重要線索。
二、湖南培養(yǎng)干細胞的應用
1.干細胞療法:湖南培養(yǎng)干細胞可用于治療多種疾病,如:
(1)心血管疾?。和ㄟ^將干細胞注射到患者心臟,可以修復受損的心肌細胞,提高心臟功能。
(2)神經(jīng)系統(tǒng)疾?。喝缗两鹕?、中風等,干細胞療法可以幫助恢復神經(jīng)功能。
(3)血液病:如白血病、再生障礙性貧血等,通過干細胞移植,可以重建正常的造血系統(tǒng)。
2.組織工程:湖南培養(yǎng)干細胞可以應用于組織工程領域,如:
(1)皮膚移植:通過培養(yǎng)干細胞,可以生成用于皮膚移植的皮膚組織。
(2)軟骨修復:干細胞療法可以用于修復受損的軟骨,緩解關(guān)節(jié)疼痛。
3.藥物篩選與研發(fā):湖南培養(yǎng)干細胞技術(shù)可以用于藥物篩選與研發(fā),為新藥研發(fā)提供有力支持。
總之,湖南培養(yǎng)干細胞在生物醫(yī)藥、疾病治療、組織修復等領域具有重要作用。隨著科學技術(shù)的不斷進步,相信湖南在干細胞研究領域的成果將會更加豐碩,為人類健康事業(yè)作出更大貢獻。
-
上一頁: 干細胞修復腎病臨床研究進展如何,效果怎樣
- 2024-09-27廣州貝拉國際醫(yī)療細胞治療效果好嗎
- 2024-10-14干細胞超低溫樣本庫公司
- 2024-11-05復活草干細胞培植技術(shù)突破?
- 2024-09-27貝拉干細胞正規(guī)嗎
- 2024-09-27艾樂貝拉干細胞正什么功能
- 2024-10-12干細胞治療自閉癥真的有效嗎?有哪些案例?
- 2024-08-29干細胞不適宜人群,干細胞移植治療禁忌癥
- 2024-10-11上海干細胞醫(yī)療中心有幾家?如何選擇專業(yè)機構(gòu)?
- 2024-10-11干細胞抗衰老技術(shù)哪家強?如何選擇正規(guī)機構(gòu)?
- 2024-09-01骨髓干細胞移植需要配型嗎,移植前的配型要求
- 2024-08-29外周血造血干細胞采集步驟及注意事項
- 2024-08-01干細胞提取過程,干細胞提取需要多少時間
- 2024-10-11陜西牙髓干細胞存儲有什么好處?如何選擇存儲機構(gòu)?
- 2024-07-24干細胞治療肝硬化,干細胞治療肝硬化效果怎么樣
- 2024-08-20為什么要存儲臍帶干細胞,這幾大好處你不能不知
- 2024-09-12吉美瑞生干細胞移植費用大概多少錢
- 2024-10-11動物干細胞治療要花多少錢?與人類干細胞治療有何不同?
- 2024-08-03什么是干細胞治療,干細胞治療有副作用嗎
